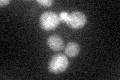
YNR039C
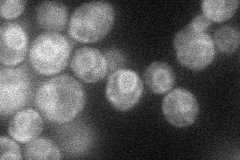
YNR039C
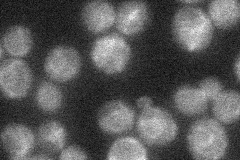
YNR039C
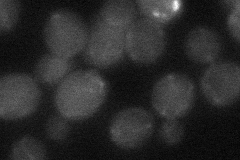
YNR039C
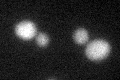
YNR039C
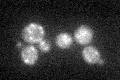
YNR039C

View description
Endoplasmic reticulum protein of unknown function, transcription is induced under conditions of zinc deficiency; mutant phenotype suggests a role in uptake of zinc
Localization:
Intensity:
Fold change:
Significance:
-
C’ GFP library in SD
ER26.67 -
N' NOP1pr-GFP in SD
ER37.8555 -
N' TEF2pr-mCherry in SD

ER12.8759 -
N' NATIVEpr-GFP in SD
ER29.0031 -
N' TEF2pr-VC and Cyto-VN in SD
below threshold28.0244 -
C’ GFP library in SD+DTT
ER21.20.79No -
C’ GFP library in SD+H2O2
ER24.020.9No -
C’ GFP library in Starvation Media

ER22.380.83No -
C’ GFP library on the background of Pup2-DaMP

ER -
C’ GFP library on the background of CCT mutant

ER19.66860.737174No
